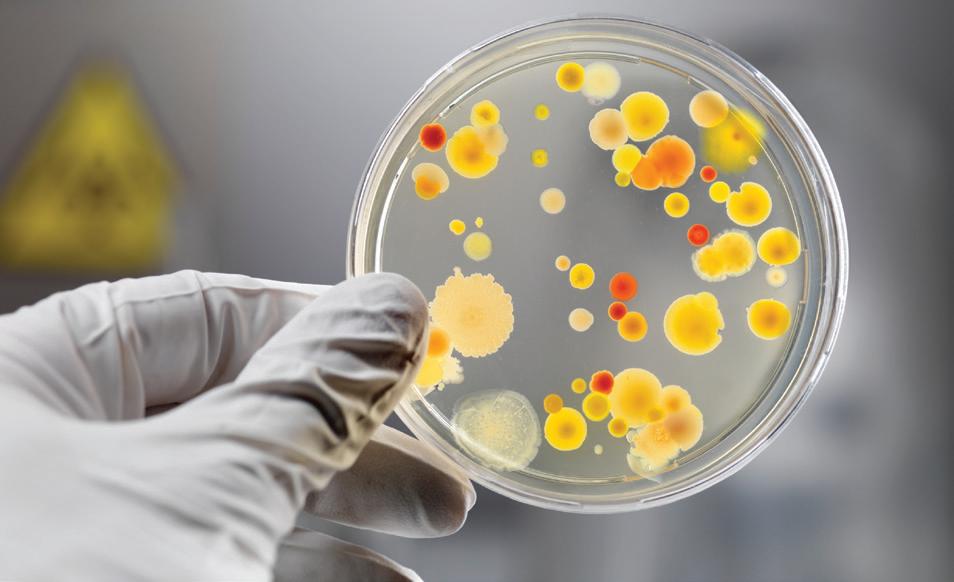

Revestimientos para pisos en la industria alimenticia





Experiencia consolidada, garantía para la industria alimenticia.
Ferrocement® es una empresa especializada en el desarrollo de sistemas para pisos industriales formulados con el fin de brindarles resistencia ante agresiones químicas, mecánicas y microbiológicas, frecuentes en entornos de industrias de procesamiento de alimentos.
Los sistemas para pisos industriales de Ferrocement® son elegidos por marcas líderes de los sectores cárnico, pesquero, avícola, lácteo, vitivinícola, agropecuario y de bebidas, ingredientes y aditivos, entre otros. Estos sistemas ofrecen una amplia variedad de terminaciones, mayor vida útil y un alto rendimiento, adaptándose a las exigencias de cada industria.
Prevención de riesgos para la producción y el consumidor
La presencia de microorganismos representa un riesgo significativo para los procesos industriales. Por ello, los revestimientos de Ferrocement® incorporan aditivos biocidas que inhiben la proliferación de bacterias, hongos y microorganismos como Escherichia coli, Salmonella, Pseudomonas y Estafilococos, cumpliendo con normativas internacionales de higiene.
Principales características de los Sistemas Ferrocement®
Impermeables
Resistentes a ataques químicos
Fácil limpieza y mantenimiento
Diseñados para maximizar la seguridad alimentaria y facilitar el mantenimiento, los pisos Ferrocement® brindan soluciones eficaces frente a los desafíos cotidianos de la industria: tolerancia a agentes químicos agresivos, resistencia al tránsito intenso y facilidad de limpieza.


El problema y la solución para Pisos Industriales
Los pisos tradicionales de hormigón o cemento carecen de resistencia suficiente frente a los agentes químicos propios del procesamiento de alimentos, provocando graves deterioros en su superficie por corrosión. Los sistemas de revestimiento anticorrosivo de Ferrocement® están especialmente formulados para proteger las superficies en procesos productivos húmedos o secos.
Contienen aditivo biocida
Rápida habilitación
Aprobado ISO 22196
Seguridad Alimentaria
Variedad de colores y texturas Aptos para alto tránsito
Opcionalmente conductivos
Usos recomendados.

Áreas de procesos húmedos o secos
Zonas expuestas a derrames de productos agresivos propios de los productos procesados en la industria alimentaria (ácidos, sales, azúcar, sangre, aceites calientes), que corroen rápidamente los pisos sin protección, deteriorando el rendimiento de la superficie.

Cleaning In Place (CIP) & Sterilization In Place (SIP)
Las soluciones de limpieza tipo CIP, como los compuestos de ácido nítrico, bases compuestas de hipoclorito requieren pisos resistentes a la corrosión química y duraderos en el tiempo, que eviten el reemplazo periódico de los revestimientos.

Áreas de empaque
Sectores sometidos al arrastre que utilicen maquinaria de transporte, como zorras apiladoras o autoelevadores, que exijan superficies resistentes, sin comprometer la higiene y la seguridad del producto en la cadena de valor.

Líneas de producción
Las líneas de producción están expuestas a derrames de productos por lo que requieren rutinas de mantenimiento y limpieza intensiva con detergentes agresivos. Los revestimientos Ferrocement® soportan las rutinas de limpieza más exigentes donde se utilizan químicos agresivos, incluso en altas temperaturas.
Terminaciones superficiales de los sistemas Ferrocement®



Terminación antideslizante. Carga Nro. 1. Textura fina. Nivel básico de resistencia al deslizamiento.

Terminación antideslizante. Carga Nro. 2. Textura media. Alta resistencia al deslizamiento.

Terminación antideslizante. Carga Nro. 3. Textura gruesa. Máximo nivel de resistencia al deslizamiento.


FERROPUR GMF®
Revestimiento poliuretánico de alta resistencia química y al desgaste para pisos industriales.
USOS
Ferropur GMF® está recomendado para las industrias que posean procesos húmedos o secos con derrames químicos en áreas donde también se requiera resistencia mecánica. Ideal para la industria alimenticia: cárnica, vitivinícola, láctea, bebidas, frutícola, panificados, entre otras.
BENEFICIOS
� Resistencia química y abrasiva
� Terminación lisa o antideslizante
� Amplia variedad de colores
� Aditivo antibiótico
� Rápida habilitación
� Fácil limpieza y mantenimiento
Zócalo Pacher 700®
Top Ferropur GMF®
300 µ a 1 mm
Ferropur GMF® & Ferropur 70®/80®
300 µ a 1 mm
Impridamp MB® o Impridamp MB Plus® Hormigón


FERROPUR MF®
Mortero poliuretánico autonivelante de alta resistencia química y mecánica para pisos de hormigón.
USOS
Ferropur MF® está recomendado para industrias que posean procesos húmedos o secos con derrames químicos, como también en áreas donde se requiera una alta resistencia mecánica, cumpliendo al mismo tiempo con altos estándares de higiene. Recomendado para industrias de bebidas, frigoríficas, embotelladoras, cervecerías, lácteas y alimenticias en general.
BENEFICIOS
� Alta resistencia química y abrasiva
� Rápida habilitación
� Amplia variedad de terminaciones y colores
� Aditivo antibiótico
� Resiste lavado a presión y alta temperatura
� Fácil limpieza y mantenimiento

Habilitación al tránsito peatonal antes de las 12 horas.
Zócalo Pacher 700®
Top Ferropur GMF®
300 µ a 1 mm
Ferropur MF® & Ferropur 70®/80® 4 a 6 mm
Impridamp MB® o Impridamp MB Plus® Hormigón

Habilitación al tránsito peatonal antes de las 24 horas.

Los sistemas Terrazo Ferropur TZ® y Pacher Monodec® se comercializan exclusivamente instalados con garantía integral de Ferrocement SA y Pisos y Revestimientos SA.
pyr.sa.com
FERROPUR TZ®
Mortero poliuretánico de alta resistencia química y mecánica para pisos industriales terrazos.
USOS
El uso de Ferropur TZ® está recomendado para toda industria que requiera alta resistencia mecánica y química en sus pisos, con una máxima vida útil, superficies de fácil mantenimiento, con un alto impacto visual y requerimientos exigentes de higiene.
BENEFICIOS
� Alta resistencia a agresiones químicas
� Alta resistencia mecánica y a la abrasión
� Amplia variedad de terminaciones y colores
� Muy fácil limpieza y mínimo mantenimiento
� Resiste lavado intensivo a alta presión y temperatura
� Aditivo antibiótico
Ferropur TZ® & Ferropur 70®/80® 8 a 12 mm


FERROPUR HF®
Mortero poliuretánico de alta resistencia química y mecánica para pisos industriales.
USOS
Ferropur HF® está recomendado para industrias que posean procesos húmedos o secos con derrames químicos, como también en áreas donde se requiera una prolongada vida útil de sus superficies cumpliendo a su vez con un alto estándar de higiene. Recomendado para industrias de bebidas, frigoríficas, embotelladoras, cervecerías, lácteas y alimenticias en general.
BENEFICIOS
� Alta resistencia a agresiones químicas
� Alta resistencia mecánica y a la abrasión
� Amplia variedad de terminaciones y colores
� Muy fácil limpieza y mantenimiento
� Resiste lavado intensivo a alta presión y temperatura
� Aditivo antibiótico

Zócalo Pacher 700® Top Ferropur GMF®
Ferropur HF® & Ferropur 70®/80® 6 a 12 mm
Hormigón Hormigón ▶ Habilitación al tránsito peatonal antes de las 12 horas. ▶ Habilitación al tránsito peatonal antes de las 12 horas.



FERROPUR SL®
Revestimiento poliuretánico autonivelante para pisos sin juntas.
USOS
Ferropur SL® está recomendado para pisos industriales de alto tránsito que requieran superficies sin juntas y un alto estándar de higiene y diseño, por su alto valor arquitectónico. Resistente a agresiones químicas y mecánicas, es ideal para procesos secos o moderadamente húmedos.
BENEFICIOS
� Protege e Impermeabiliza la superficie
� Resistente a grasas, aceites y combustibles
� Resistente a ácidos comunes, cáusticos y sales
� Es flexible, ideal para el tomado de juntas y fisuras
� Fácil limpieza
� Aditivo antibiótico


PACHER SL®
Mortero epoxi autonivelante para revestir pisos de hormigón.
USOS
Pacher SL® está recomendado para pisos industriales de alto tránsito que requieran superficies con un alto estándar de higiene y valor estético. Resistente a agresiones químicas y mecánicas, es elegido además por su alto valor arquitectónico. Ideal para procesos secos o moderadamente húmedos.
BENEFICIOS
� Protege e Impermeabiliza la superficie
� Resistente a grasas, aceites y combustibles
� Resistente a ácidos comunes, cáusticos y sales
� Fácil limpieza
� Aditivo antibiótico






PACHER 300® PACHER WASH®
Revestimientos epoxi de bajo espesor, resistentes a ataques químicos.
USOS
Pacher 300® es ideal para sellar y proteger pisos de hormigón ante la corrosión por exposición a químicos producidos en las distintas industrias o para aquellas áreas que requieran un alto control de higiene. Ideales para áreas de tránsito moderado con procesos secos o parcialmente húmedos.
BENEFICIOS
� Ideal para higiene extrema
� Protege e impermeabiliza la superficie
� Resistente a grasas, aceites y combustibles
� Resistente a ácidos comunes, cáusticos y sales
� Aditivo antibiótico
Zócalo Pacher 700®
Pacher 300®
200 a 300 µ
Impridamp MB® o Impridamp MB Plus®

Mortero epoxi para el tomado de juntas antiácidas entre cerámicas.
USOS
Pacher Wash® está especialmente recomendado en áreas con cerámicas antiácidas donde las juntas requieran alta higiene, resistencia química, mecánica y que se encuentren expuestas al uso constante de agua tanto en la operación como en su limpieza. Recomendado para industrias de bebidas, embotelladoras, cervecerías, láctea y alimenticia en general.
BENEFICIOS
� Resistente a la humedad permanente
� Resistente al lavado a presión
� Muy fluido y fácil de trabajar
� Alta resistencia mecánica y química
� Alta adherencia a cerámicas
� Aditivo antibiótico
Junta epoxídica Pacher Wash®
Mortero de asiento Groutex EP® o Groutex®


Calidad y respaldo
Ferrocement® desarrolla productos químicos y tecnologías innovadoras basados en una extensa experiencia y rigurosos ensayos técnicos, orientados a resolver las necesidades reales de profesionales, aplicadores y profesionales de la industria de la construcción.
Ferrocement® está certificada por IRAM – Instituto Argentino de Normalización y Certificación – en normas IRAM-ISO 9001-2008 en la gestión de la calidad para la producción y comercialización de productos cementíceos, poliméricos, aditivos minerales y orgánicos para la industria de la construcción.
Los sistemas Ferropur® y Pacher® de Ferrocement® incorporan un efectivo aditivo antibiótico que actúa como agente de inhibición antimicrobiana, conforme a la norma ISO 22196. Están especialmente diseñados para industrias con altos requerimientos de salubridad e higiene, y que deban cumplir con los estándares del sistema HACCP
Ante cualquier requerimiento técnico específico, es posible recibir asesoramiento de un Representante Técnico de Ferrocement®, quien podrá colaborar en la búsqueda de la solución adecuada para su proyecto. También puede encontrar más información en: ferrocement.com.ar
Oficinas comerciales y Planta industrial Av. Presidente Perón 9430 (B1714OMQ) Ituzaingó, Buenos Aires. Argentina. Tel (+54 11) 4621 2991
ferrocement.com.ar